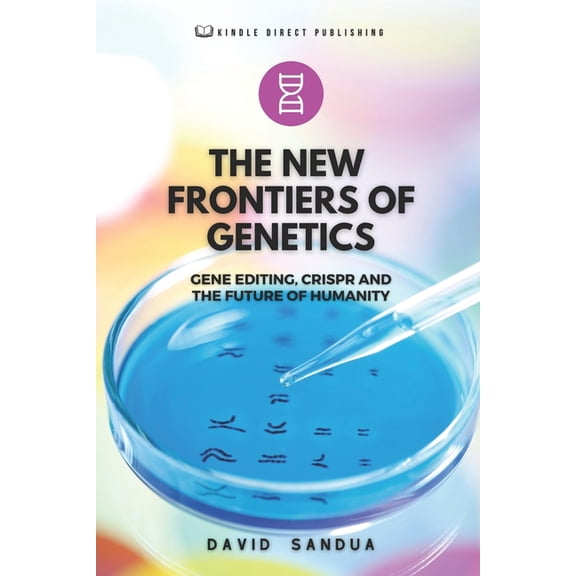
The New Frontiers of Genetics: Gene Editing, Crispr and the Future of Humanity

Pre-Owned BooksPre-Owned Children's BooksPre-Owned Fiction BooksReference BooksAges 3-5 Children's BooksAges 3-5 Kids' BooksAges 6-8 Kids' BooksAges 9-12 Kids' BooksBiotechnology BooksEnvironmental Law BooksEthics & Moral Philosophy BooksFiction NovelsGeneral Medical BooksGenetics BooksHuman Rights Political BooksImmunology BooksInternational Law BooksLaw BooksLegal Research BooksLiterary Summaries & NotesMedical Biographies & MemoirsMedical BooksMedical Ethics BooksMedical Law & Legislation BooksNature BooksPhilosophy BooksPhotography BooksPolitical BooksReligion & Religious Studies BooksScience & Technology Biographies & MemoirsScience BooksScience Fiction & Fantasy BooksScience, Nature & Technology Kids' BooksSocial Science BooksStudy Aids & Test Prep BooksTechnology & Engineering BooksWomen Biographies & Memoirs
Pre-Owned BooksPre-Owned Children's BooksPre-Owned Fiction BooksReference BooksAges 3-5 Children's BooksAges 3-5 Kids' BooksAges 6-8 Kids' BooksAges 9-12 Kids' BooksBiotechnology BooksEnvironmental Law BooksEthics & Moral Philosophy BooksFiction NovelsGeneral Medical BooksGenetics BooksHuman Rights Political BooksImmunology BooksInternational Law BooksLaw BooksLegal Research BooksLiterary Summaries & NotesMedical Biographies & MemoirsMedical BooksMedical Ethics BooksMedical Law & Legislation BooksNature BooksPhilosophy BooksPhotography BooksPolitical BooksReligion & Religious Studies BooksScience & Technology Biographies & MemoirsScience BooksScience Fiction & Fantasy BooksScience, Nature & Technology Kids' BooksSocial Science BooksStudy Aids & Test Prep BooksTechnology & Engineering BooksWomen Biographies & Memoirs
Gene Editing Human
Uses item details. Price when purchased online